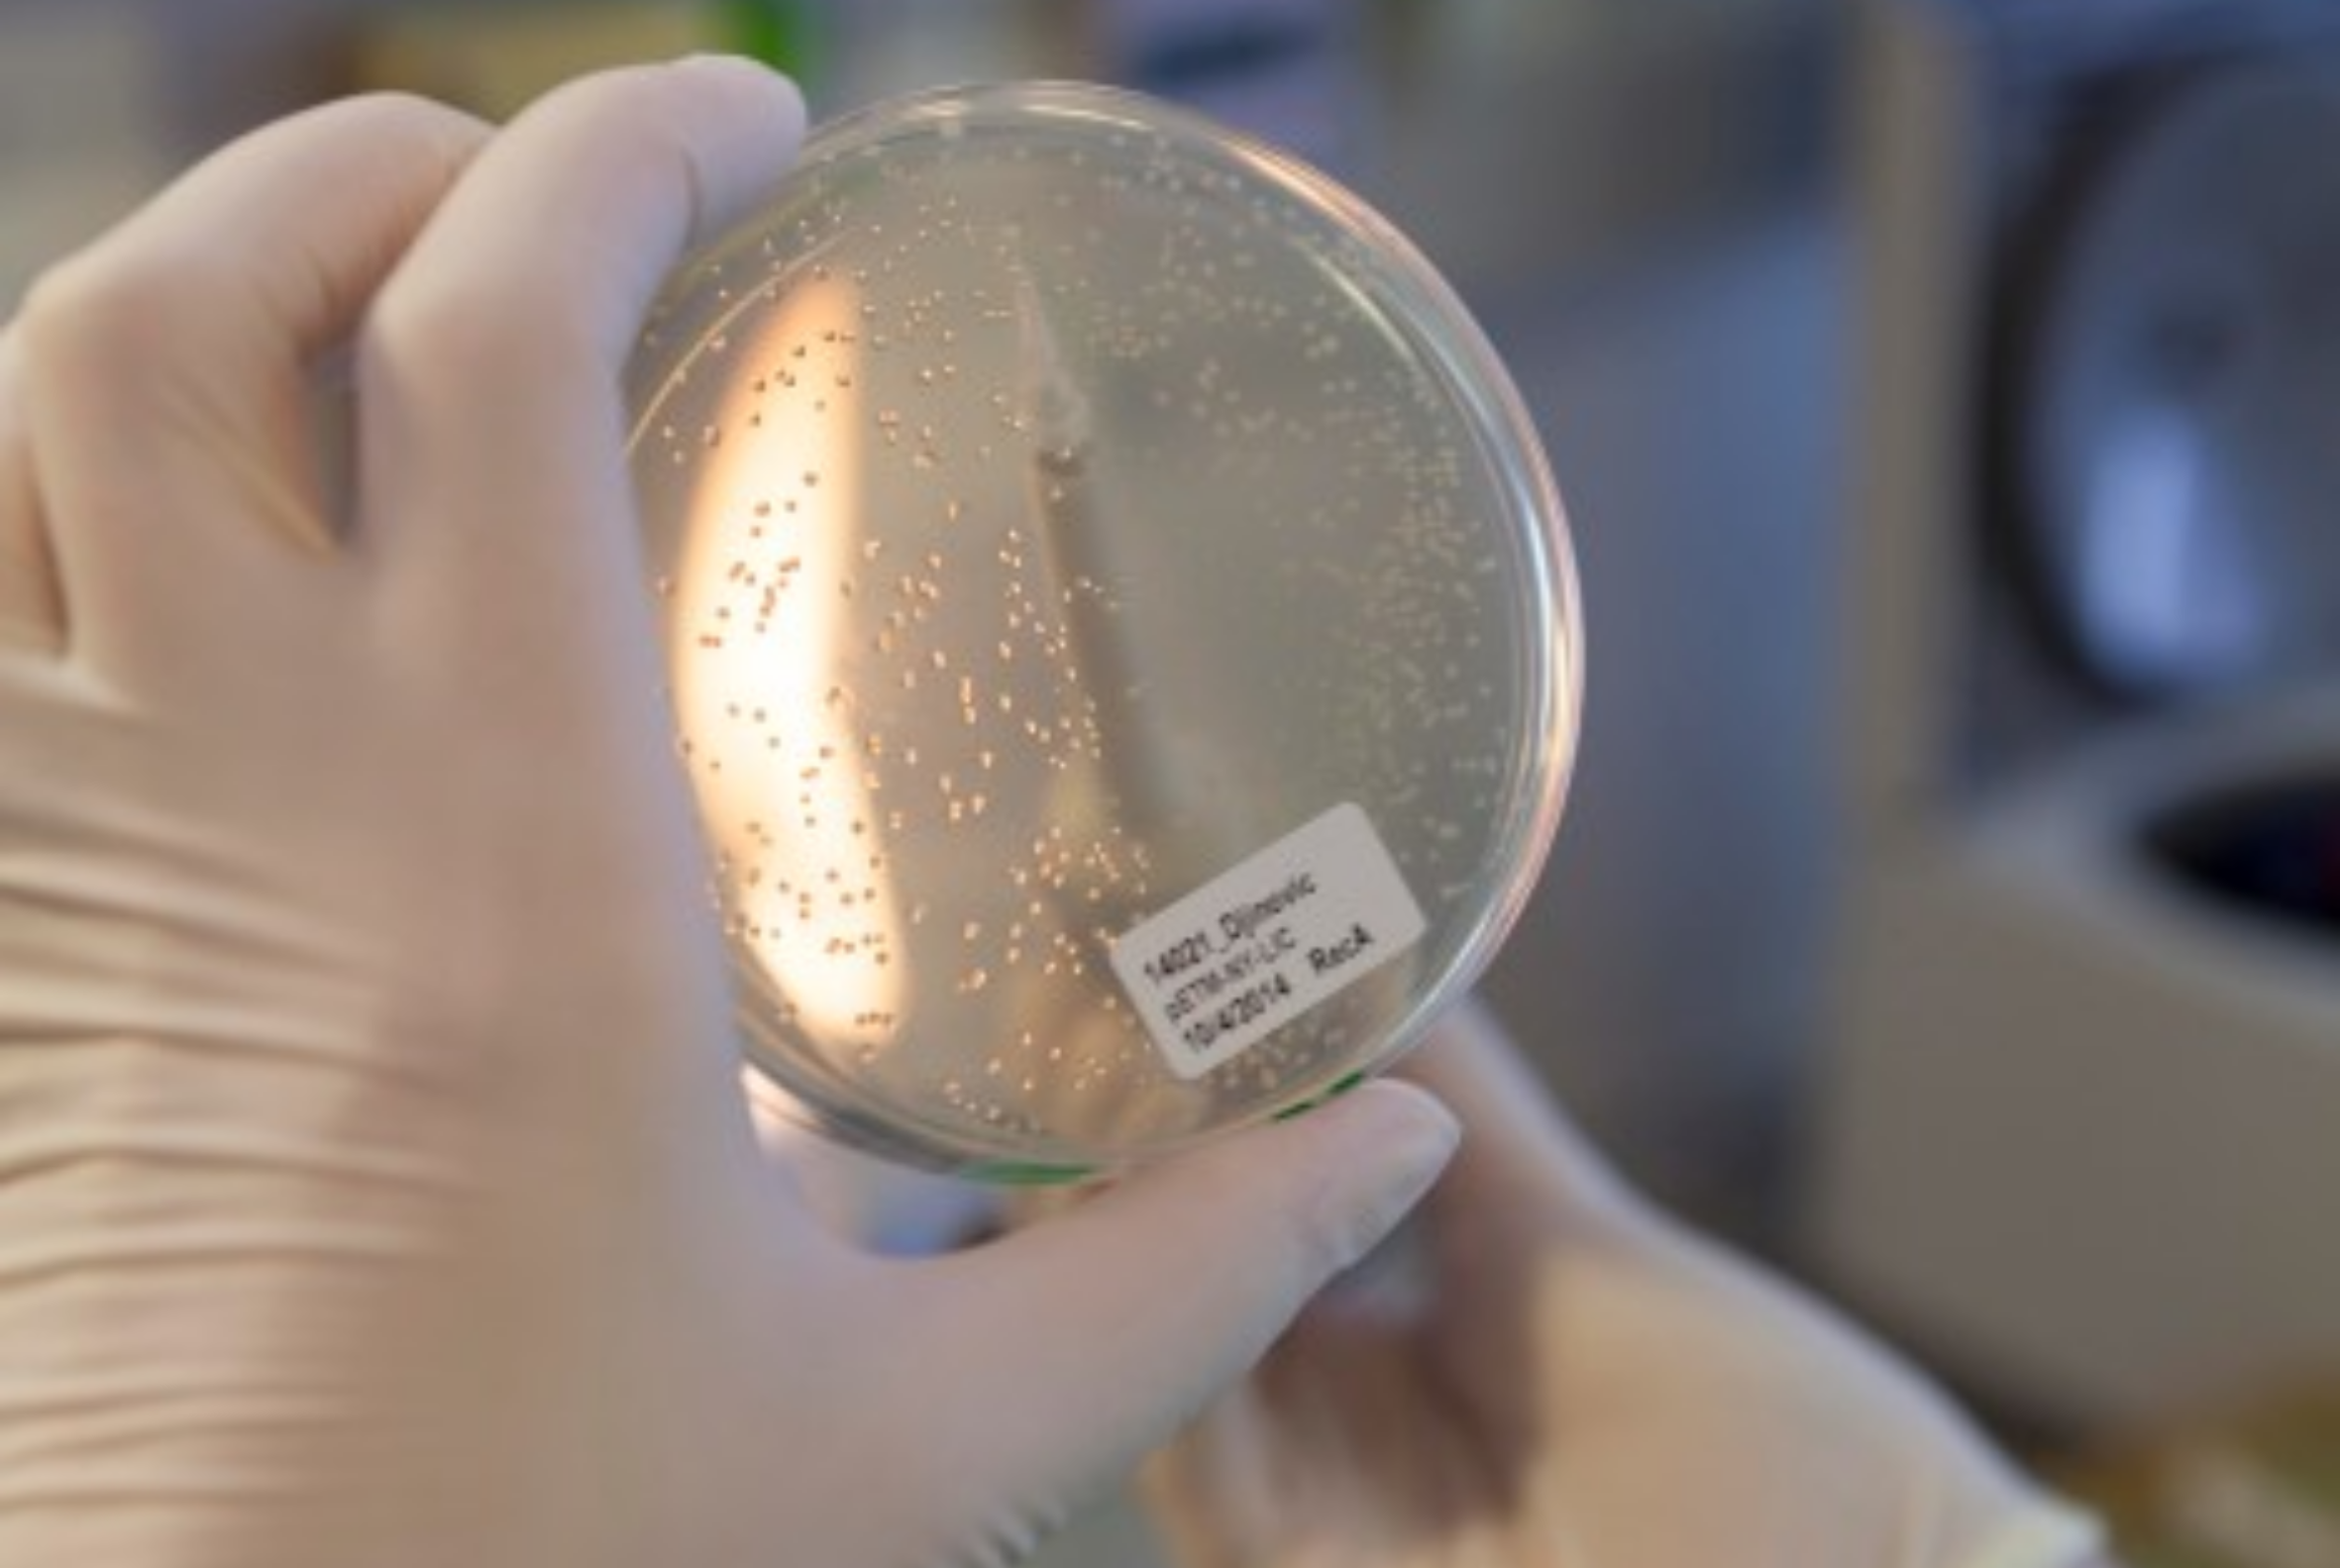
Agar plate picture

Molecular cloning
We offer a wide-range of traditional and modern molecular biology techniques alongside an extensive library of vectors suitable for bacterial, insect, and mammalian systems.
Bacterial expression (E. coli)
For expression in E. coli, we use common backbones facilitating inducible expression from T7 promoter and offering a wide range of tags for purification or detection purposes.
Baculovirus expression (BEVS) in insect cells
For creating expression constructs for the BEVS pipeline, be it for single-gene expression or multi-gene expression from the same construct, we utilize an in-house developed system called GoldenBac (Neuhold et al., 2020).
Transient mammalian expression (HEK 293)
For transient expression in the mammalian system, we usually clone the genes into a backbone with the strong constitutive promoter CAG.
Stable pool mammalian expression (HEK 293)
We utilize a modular vector system equipped with PiggyBac transposition elements and an inducible promoter that also allows for free choice between several antibiotic selection markers.
Gene synthesis
Should you want to initiate a cloning request, but not have a sequence-verified template for your gene of interest, we can take over the synthesis order and place it with one of the leading vendors on the market.
Custom-cloning
Upon request, we also take on highly customized cloning projects. The main pre-requisite for such a project is a well-defined goal and verified starting material.
Order forms
When opening a new ticket to request a service, please download the relevant form for your chosen system:
- cloning
- BEVS
- HEK293
Please complete the form and attach it to your ticket.